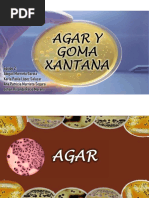

0% encontró este documento útil (0 votos)
33 vistas6 páginasAgar
El Agar-Agar es un polisacárido extraído de algas rojas, utilizado principalmente como agente gelificante y espesante en diversas industrias, incluyendo alimentos y farmacología. Su estructura química incluye dos fracciones principales: Agarosa y Agaropectina, y presenta propiedades únicas como gelificación a bajas concentraciones y resistencia a la degradación microbiana. El proceso de producción implica varias etapas, desde el secado de las algas hasta su extracción y procesamiento para obtener el producto final.
Cargado por
PabloMartinezDerechos de autor
© © All Rights Reserved
Nos tomamos en serio los derechos de los contenidos. Si sospechas que se trata de tu contenido, reclámalo aquí.
Formatos disponibles
Descarga como DOC, PDF, TXT o lee en línea desde Scribd
0% encontró este documento útil (0 votos)
33 vistas6 páginasAgar
El Agar-Agar es un polisacárido extraído de algas rojas, utilizado principalmente como agente gelificante y espesante en diversas industrias, incluyendo alimentos y farmacología. Su estructura química incluye dos fracciones principales: Agarosa y Agaropectina, y presenta propiedades únicas como gelificación a bajas concentraciones y resistencia a la degradación microbiana. El proceso de producción implica varias etapas, desde el secado de las algas hasta su extracción y procesamiento para obtener el producto final.
Cargado por
PabloMartinezDerechos de autor
© © All Rights Reserved
Nos tomamos en serio los derechos de los contenidos. Si sospechas que se trata de tu contenido, reclámalo aquí.
Formatos disponibles
Descarga como DOC, PDF, TXT o lee en línea desde Scribd